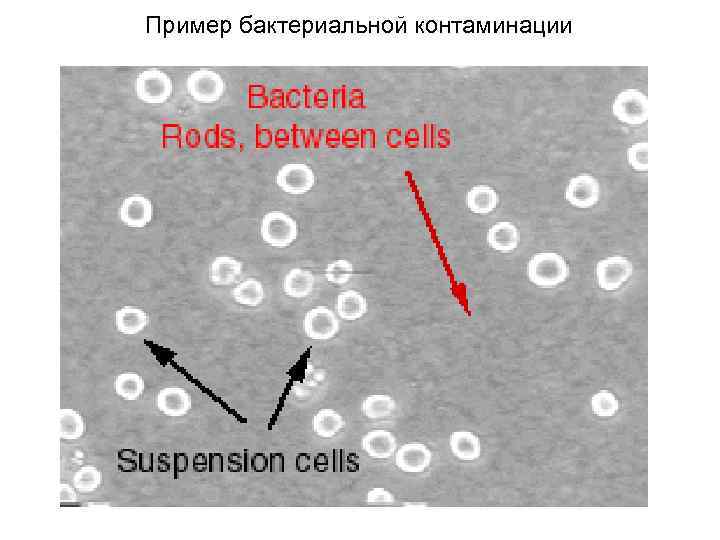
Пример бактериальной контаминации
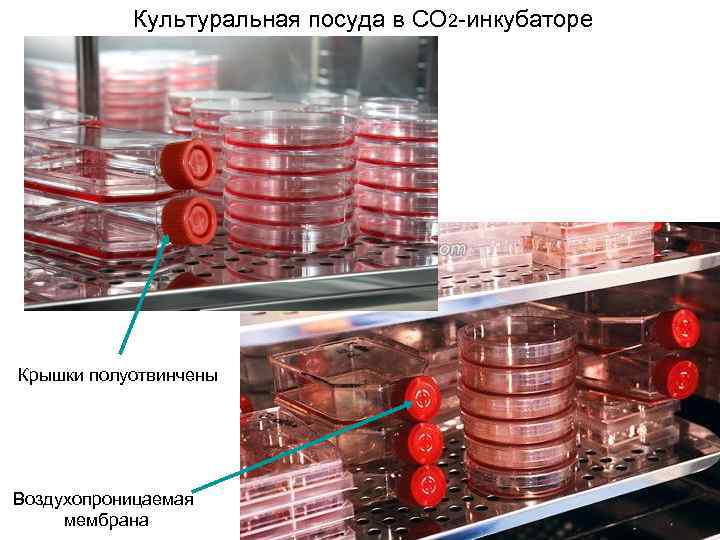
Культуральная посуда в CO 2 -инкубаторе Крышки полуотвинчены Воздухопроницаемая мембрана

ppt-2003 Организация лаборатории клеточного кул..
- Количество слайдов: 41

Курс: «Медицинская клеточная биотехнология» Организация лаборатории клеточного культивирования Кафедра физиологии человека и животных Биологического факультета Дон. НУ Лектор: ст. преподаватель кафедры Турчин Виктор Васильевич Донецк, 2013

Общая схема организации лаборатории клеточного культивирования

Ламинарный шкаф II класса микробиологической защиты с вертикальным потоком воздуха

Вертикальный поток воздуха

Ламинарный шкаф II класса микробиологической защиты с вертикальным потоком воздуха

Ламинарный шкаф II класса микробиологической защиты с горизонтальным потоком воздуха

Горизонтальный поток воздуха

Ламинарный шкаф II класса микробиологической защиты с горизонтальным потоком воздуха

Воздушный шлюз (соединяет стерильную зону со вспомогательными помещениями)

CO 2 -инкубатор Контроль: Температуры Влажности Атмосферы: *CO 2 *O 2 (? )

CO 2 -инкубатор с установкой для суспензионных культур Шейкер

CO 2 -инкубатор большой ёмкости CO 2 -инкубатор с установкой для роллерного культивирования

Инвентированный микроскоп

Охлаждаемая центрифуга

Лабораторный термостат Сухожаровый шкаф

Водяная баня Портативный автоклав

Деионизатор воды

Лабораторные холодильники -20 ºС +2 -- +8 ºС -70 -- -86 ºС (ультранизкотемпературные)

Програмный замораживатель

Изопропаноловая камера Криопробирки

Криохранилища малого объёма

Криохранилища большого объёма

Лабораторная одежда стандарта GMP

Пример грибковой контаминации

Пример бактериальной контаминации
Пример бактериальной контаминации

Пример бактериальной контаминации

Микоплазменная инфекция Фибробласты здоровые Микоплазма (электронная микроскопия) Размер бактериальной клетки < 1 мкм (не обнаруживаются при помощи световой микроскопии) Заражённые микоплазмой

Микоплазменная инфекция Детекция микоплазмы методом ПЦР с электрофарезом

Микоплазменная инфекция Детекция микоплазмы методом флуоресцентного окрашивания (краситель Myco. Fluor) Не заражённая культура Заражённая культура

Стандартные культуральные флаконы

Культуральные чашки Петри

Культуральные флаконы большой ёмкости

Культуральные флаконы большой ёмкости

Культуральные флаконы большой ёмкости

Многолуночные планшеты

96 -луночный планшет МТТ тест

Вставки для многолуночных планшетов

Культуральные ячейки на слайдах для микроскопии
Культуральная посуда в CO 2 -инкубаторе Крышки полуотвинчены Воздухопроницаемая мембрана

Бутыли для суспензионных культур Магнитная мешалка
ppt-2003 Организация лаборатории клеточного кул..